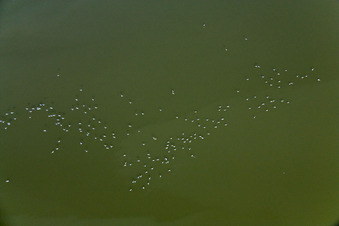
Luftbild von Wasservögel am Ammersee im Bundesland Bayern, Deutschland
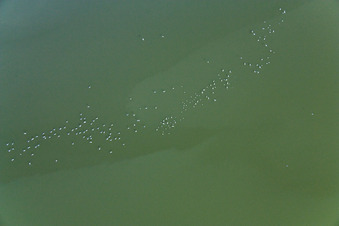
Wasservögel am Ammersee im Bundesland Bayern, Deutschland

Marker und Pins sind, wo es Luftbilder gibt:
 zoomed dort,
zoomed dort,  zum Luftbild dort,
zum Luftbild dort,  zum Album des Nachbarorts.
zum Album des Nachbarorts.
Hier bestellen Sie bitte Ihre Luftbilder von außerhalb Deutschlands.
(Wenn Sie Luftbilder aus Deutschland im Warenkorb des Online-Shop haben, bezahlen Sie bitte in der Online-Shop-Kasse .)
(Wenn Sie Luftbilder aus Deutschland im Warenkorb des Online-Shop haben, bezahlen Sie bitte in der Online-Shop-Kasse .)